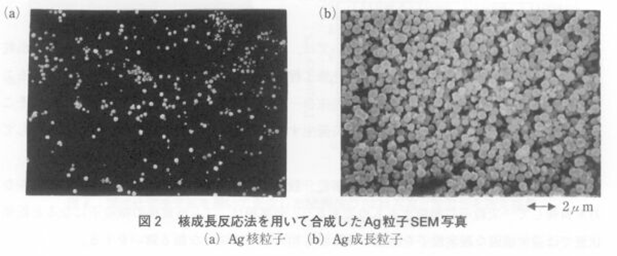

| 일 | 월 | 화 | 수 | 목 | 금 | 토 |
|---|---|---|---|---|---|---|
| 1 | 2 | 3 | 4 | 5 | 6 | 7 |
| 8 | 9 | 10 | 11 | 12 | 13 | 14 |
| 15 | 16 | 17 | 18 | 19 | 20 | 21 |
| 22 | 23 | 24 | 25 | 26 | 27 | 28 |
- Barium titanate
- dispersion
- microstructure
- reliability
- ASSB
- CERAMIC
- nano powder
- ni-paste
- C0G
- ZrO2
- paste
- NI-MLCC
- core-shell
- Zirconia
- hydrothermal
- X8R
- BaTiO3
- oxygen vacancy
- halt
- Powder
- Sintering
- Automotive
- nickel
- mlcc
- X7T
- CSZT
- bme
- coating
- Murata
- EV
- Today
- Total
MLCC Material & Process
제4장 1절 전극재료 합성기술 - 액상법 본문
Daiken Ueyama
4.1 액상법(습식화학환원법)
서론
유전체에 산화티탄(TiO2)을 사용한 디스크 콘덴서가 1930년대에 독일(HESHO)에서 개발되었다. 그것을 받아 1935년에는 일본에서도 川端제작소나 村田(murata)제작소등의 회사가 차차 창업하여 디스크 콘덴서 생산을 시작하였다. 한편 1940년대가 되면서 산화티탄 콘덴서의 개량을 위해, 산화티탄(TiO2)에 산화 바륨(BaO)이나 산화마그네슘(MgO), 산화 칼슘(CaO) 등을 복합화하는 연구가 성행하였다. Waku등은 고유전율을 갖는 티탄산바륨을 발명하였다. 그 발명으로 인해 세라믹 콘덴서의 성능이 현저하게 향상되었다.
그 후 콘덴서의 편리성은 텔레비젼를 시작으로 각종전자기기로의 수요를 불러 일으켰다. 그래서, 콘덴서 maker에서의 양산이 급속화하고, 그 전원으로서 필수 불가결한 전극재료의 개발도 활발해졌다. 이것을 계기로 세라믹 콘덴서 재료는 물론 Cu, Ni, Pd등의 미립자를 사용한 전극 재료의 합성기술이나 콘덴서 제조 프로세스 기술이 고도로 발전하게 되었다. 그래서 1990년대는 드디어 입경 1㎛의 pd미립자를 이용한 고적층 칩 콘덴서의 대량생산에 돌입하게 되었다. 이 흐름이 머무를 곳을 모른 채 2000년에 들어온 지금에서는 비금속인 Ni 미립자 0.5 ㎛를 사용하여 유전체 막 두께 3㎛, 전극 막 두께 1.5㎛, 적층수 300층, 용량 10μF의 칩 콘덴서가 대량 생산되었으며, 연구레벨은 Ni 미립자 0.2㎛이하를 사용하여 유전체 막 두께 2㎛, 전극 막 두께 1㎛이하에서 500층, 22μF로의 전개라는 예상을 훨씬 넘은 초고적층 대용량화 시대로의 큰 흐름 속으로 급전개되고 있다.
이러한 흐름 중에서, 필자들은 적층 세라믹 콘덴서 프로세스 연구에 들어서서 거의 20년 전에 device maker의 기술자로부터 LSI나 leadless칩을 표면실장하고 싶다는 이유로 수십층 이상의 적층 세라믹 디바이스의 연구를 진행하고 싶다는 공동 연구 의뢰를 수 차례 받은 적이 있다. 당시의 개발목표는 전부 실현 되었다고는 할 수는 없지만, 그래도 현재는 그것을 기초로 500층 이상의 초고적층 세라믹콘덴서를, 그리고 200mm X 200mm의 대형 사이즈에는 100층에 육박하는 초고밀도 디바이스의 개발을 향해 착실히 추진을 계속해가는 것은 두말할 나위가 없다.
한편 트랜지스터의 발전의 끝을 가져온 고실장 고밀도 일렉트로닉의 발전은 두드러져서 LSI연구는 초 LSI시대로 급전개되고 있다. 이 고밀도 실장기술의 발전을 계기로 재료 적층프로세스 기술이 크게 전개되어 2000년대에는 IT혁명으로 인해 또 다른 기술혁신이 기대되고 있다. 이들 LSI나 일렉트로닉 실장기술과 고적층 프로세스기술은 지금까지 독립적으로 발전해 왔지만 양 기술간에는 그 정도의 큰 간격은 보이지 않는다. 예전에는 디바이스의 박막 초고적층화의 흐름과 컴퓨터 시스템 기술의 약진은 양 기술간의 있던 간격을 메우고, 양 기술의 융합에 의한 신기술 창출도 기대되고 있다.
필자들은 그 박막 초고적층화의 흐름의 일환으로 습식화학 환원법에 의한 독립 단분산 구상 초미립자의 합성에 대해서도 연구하고 있다. 그 동기로서 이들 연구가 신재료 신기능을 창출하여 21세기에 필요한 초고밀도 초고용량을 실현하는 초고적층 세라믹디바이스의 개발에 중요하리라고 사료되기 때문이다.
이 논문에서는 이것을 명제로 고적층 세라믹 콘덴서에 사용되는 전극재료의 액상합성법(습식화학 환원법)에 대해 개략적인 설명한 다음, 단분산 구상 금속미립자의 합성에 대해 필자들의 최근 연구를 중심으로 현상에 대해 서술하고자 한다.
1. 단분산 구상 미립자의 필요성
적층 세라믹 콘덴서(MLCCC)는 소형, 고성능화가 용이하게 되어 수요가 급격히 진전되고, 이에 따라 MLCC의 고용량화가 강하게 요구되어졌다. 형상을 바꾸지 않고, 고용량화를 실현시키기 위해서는 유전체층뿐만 아니라 내부전극의 박층화, 고다층화가 급선무이다. 이를 이루기 위해 내부전극 1층당 막 두께는 1.5㎛부터 1.0㎛까지 박층화해 오고 있다. 그러나 유전체층이나 내부전극의 박층화는 잘 알려져 있듯이 층간의 단락이나 단선불량을 일으키고, 콘덴서불량의 주원인중 하나인 구조결함을 발생시키기 쉽다. 이 층간에서의 단락이나 단선을 피하기 위해서는 유전체 및 내부 전극에 사용되는 분체 원료는 입경이 0.5㎛부터 1.0㎛ 정도로 미세하고, 또한 응집입자가 없고 충분히 분산한 일차입자이어야 하는 것이 요구된다.
현재 내부전극에 사용되고 있는 금속분의 제조방법에는 CVD법 등의 기상법이나 분무 열분해법 등에 의해 합성한 분체가 많다. 그러나 CVD법이나 분무 열분해법에 의한 금속분체는 종래의 습식화학 합성법으로 합성한 금속 분체에 비해 응집입자의 생성이 매우 적지만, 박층화시에 있어서 기피되는 조대 입자가 많이 생성되는 결점을 가지고 있다. 또한 상기의 방법에서는 장치가 고가이고 금속 분체의 저가격화라는 관점에서도 문제가 된다.
그래서 필자들은 응집입자를 생성하기 쉬운 결점을 갖지만, 입경이나 입도분포의 제어가 용이하고 또한 제조 cost가 저럼하며, 대량생산성이 우수한 종래의 습식화학 합성법에 주목하였다. 그래서 습식화학 합성법으로 응집입자가 존재하지 않는 단분산 구상 미립자를 합성하는 방법으로서 아래에 2가지 합성방법을 제안하였다2,3).
1) 합성 시부터 응집입자가 없는 단분산 구상 미립자를 합성하는 방법
2) 합성 시에 존재하는 응집입자를 해쇄하여 단분산 미립자를 합성하는 방법
그리고 이 2가지 방법을 이용하여 합성한 금속 분체를 세라믹 콘덴서 전극 paste에 응용하여 paste 특성과 응집입자의 관계를 검토하였다. 이하에 그 일부에 대해 구체적으로 소개하겠다.
2. 액상법(습식화학환원법)에 의한 단분산 구상 미립자의 합성
2.1 금속미립자의 제조방법
도전paste 재료에 널리 사용되는 금속 미립자의 합성 방법에 대해서는 표1에 나타낸 것처럼 몇개의 방법을 들 수 있다. 그 중 한가지로서 금속염 용액으로부터 환원반응에 의해 은, 금, 백금,팔라듐 등 귀금속이나 니켈, 동 등의 비금속의 미립자를 얻는 방법이 있다. 이것이 액상법(습식화학 환원법)이다. 환원제는 기본적으로 환원하는 용액이 산성용액인가 알칼리 용액인가 중성용액인가에 따라 다르다. 이하에서는 귀금속 분말을 예를 들어 구체적으로 환원반응을 예시해 본다.
① 은
은염으로서는 초산은이 일반적으로 사용된다. 기산에 의한 환원반응은 (1)식처럼 표시된다. 생성된 초미립자의 Ag(수㎚~수10㎚)가 상호적으로 충돌 합체하여 미립자 분말을 생성한다고 생각된다.
2Ag+ + HCOOH → 2Ag + 2H+ + CO2 (1)
② 금
금 화합물에는 염화 제이금산HAuCl4가 사용되어진다. HAuCl4은 알칼리 용액중에서 (2)식에 따라 과산화수소에 의해 환원되어 금미립자분말을 생성한다.
2Au3+ + 2H2O + 6OH- → 2Au + 6H2O +3O2 (2)
③ 백금
백금 화합물에는 염화 제이백금산 H2PtCl6이 사용되어진다. H2PtCl6은 알칼리 용액중에서 포름알데히드에 의해 (3)식과 같이 환원되어 백금의 미립자분말을 생성한다.
H2PtCl6 + HCHO + 6OH- → Pt + 6Cl- + 5H2O + CO2 (3)
표 1 금속미립자의 제조방법

2.2 핵생성-성장반응 합성법
습식화학 환원법으로 단분산 미립자를 합성하는 경우, 합성온도, 응집완화제, 용매농도, 3요소의 제어가 중요하다. 구체적으로 단분산 입자의 합성에는 환원속도가 밀접하게 관계하고 있다. 결국 단분산 입자의 합성조건은 저온의 합성온도이고, 적당량의 응집완화제를 첨가하고 용매농도를 희박하게하는 것이 중요하다는 것을 필자들의 실험으로 알아냈다.
그래서 단분산 입자의 생성법의 기본인 LaMer의 방법에 기초하여 저자들은 단분산 은분을 합성할 때에, 희박한 초산은 용액중에서 Ag의 핵생성 및 생성핵입자의 성장이라는 『2단계성장법을 통해 독립단분구상Ag입자의 합성방법』을 제안하고 있다.
그림1에는 LaMer에 의해 입자의 생성과 성장을 모식도적으로보여주고 있다.

용질을 소량 첨가하면 일단 용질농도는 증가하든가 첨가와 동시에 환원반응이 시작되고 그렇지 않은 용액속의 용질 농도는 단시간에 극대치를 거처 재차 감소하며 최종적으로 과포화농도로 떨어진다. 그 과정은 아래의 세번째 영역으로 분류될수 있다.
반응계에는 용질을 연속적으로 첨가하면 용질농도는 일단은 증가하든가 평형용해도 Cs를 초과하고, 용질은 이이상 용해되지 않기 때문에 반응계의 농도는 과포화상태가 된다.(Ⅰ영역)
다시 용질 농도를 증가시키면 Cmin에서 핵생성이 시작되고, 핵생성이 시작되면 용질이 급격하게 소비되기 때문에 용질농도는 증가를 멈추고 공급과 소비가 균일하게 되도록 최대 용질농도 Cmax를 취한다(Ⅱ 영역). 핵생성이 시작됐을 때 용질의 공급을 정지하면 용질농도는 바로 떨어지며, 과포화도가 낮아지기 때문에 새로운 핵 생성이 정지된다(Ⅲ영역). 성장할 수 있는 임계핵의 크기는 난용성 염에서 수십분자 정도의 결합이라고 하며 합성 핵은 1㎚정도로 생각된다.
그림2는 핵성장 반응법에 의해 실제로 핵발생 입자부터 단계적으로 성장되는 경우의 SEM사진을 보여 준 것이다. SEM사진으로부터 알 수 있듯이 초기에 성장한 핵 입자는 성장이 보여지고 있으며 평균입경이 0.1㎛부터 0.5㎛까지 변화하고 있다. 또한 0.5㎛까지 성장된 Ag입자는 응집도 없고 독립 단분산 구상입자로 성장하고 있다.
합성된 핵입자가 단결정상 입자로 성장하는 생성기구로서는 아래의 두 가지 기구를 생각할 수있다. 하나는 미즈타니 등이 제안한 결정성장이다. 이것은 나선 전이의 terrace나 kink에 용질분자가 흡착되고 표면확산에 의해 이동하여 결정에 만드는 생성기구이다. 한편 또 하나는 Matijevic등에 의해 제안된 생성기구이다. 이것은 용질분자가 핵의 표면에 흡착한 결과, 2차원의 다핵층 성장이 전 표면에서 일어난다는 생성기구이다. 그러나 필자들의 실험에서 생성된 입자핵에는 미즈타니가 제안한 생성기구인 전이의 존재는 생각하기 어려우며, Matijevic등에 의한 생성기구의 방향이 타당하다고 생각된다. 즉 그림 3에 나타낸 TEM사진으로부터 필자들의 실험에서 얻어진 단결정상 분말입자도 동일한 부착반응식으로 성장하는 것이고 핵을 중심으로 치밀한 성장이 진행되며, 기공이나 Void가 없는 진밀도에 가까운 단결정상의 분말을 형성했다고 생각된다.

표2는 통상의 습식화학환원법으로 합성한 응집입자가 다수 존재하는 종래법의 입자(a)와 핵생성 성장반응법에 의한 입자 (b)의 BET법대해 비표면적과 TAP밀도 값을 표시한 것이다. 표2에 의해 명확하게 핵생성 성장반응법을 사용하여 합성한 입자는 통상의 응집이 다수 나타나는 종래법에 의한 입자에 비해 비표면적이 작고 TAP밀도가 높다. 이것으로부터도 핵생성 성장반응법으로 합성된 금속 입자는 단분산입자로 있는 것이라고 말할 수 있다.
표 2 Ag분말의 분체특성

2.3 응집입자해립법
단분산미립자를 합성하는 방법인 습식화학환원법으로서 전항에서 상세히 설명한 핵생성 성장반응법만은 분말의 양산성을 고려한 경우 생산 효율면에서 엄밀히 문제가 되고 있다. 통상 액상법(습식화학환원법)에 대해서는 필연적으로 액체중에서 분산한 금속분말은 유출건조후, 분말화하여 회수한다. 그러기 위해서는 건조공정에 의한 매우 강고한 재응집입자를 생성하는 것은 피할수 없다. 이러한 응집은 분말의 일차입자크기가 작으면 과연 현저하게 일어난다. 그리고 분말로 회수하는 건조공정에 의해 발생하는 응집입자를 기계적으로 일차입자까지 해립하여 단분산 미립자를 얻는 방법이 있다.
그 응집입자의 해립법은 응집입자의 해립분산기술을 적용한 건조 및 습식으로 mechenical한 힘을 부하하여 일차 입자로 해립하는 것이다. 금속분은 1㎛전후로 미립자가 되면 건조상태에서는 통상 강고한 응집입자를 형성하 조대입처럼 --- 그리고 필자들은 해립입자의 재응집은 아래 방법으로 제어하였다.
결국 금속분말과 직접화학결합을 형성하는 반응성유기화합물을 첨가하고 그 존재하에서 응집입자에 강한 mechenical 전단력을 가하여 응집입자를 해립하여 재응집을 제어하였다. 이것은 해립으로 생성된 신생입자표면에 mechenical 반응을 일으켜 유기금속화합물의 자기조직막을 입자표면에 형성하여 제어하는 것이다. 그러나 기계적으로 해립하는 경우 대상물이 금속인 경우에 금속입자에는 전성이나 연성이라는 특성이 있다. 그러므로 일차입자에 해립할 때 입자의 변형에 충분히 주의할 필요가 있다.
그림4에는 필자가 현재 고적층 세라믹 콘덴서의 내부전극용을 대상으로 하여 생산하고있는 Ni 분말의 (a)해립전과 (2)해립처리후의 (1)SEM사진과 (2)입도분포측정결과를 보여주고 있다. 그림 4(a)(b)에 보여주고 있는것 처럼 응집입자는 해립처리를 한 것으로 일차입자가 변형한 것이 아니고 순차적으로 단분산 입자에 해립되어지는 것을 알수있다.
한편 여기에서는 혼재되어 있지 않으나 해립슬러리를 사용하여 건조된 그대로 측정할 때의 입도분포는 앞에 보여준 그림 4(b)의 (2)와 전부 동일하다.

그 경우로부터 입자표면에 형성된 유기자기조직막이 건조되어 생기는 해립입자의 재응집을 제어하는 것도 분명하게 된다. 또한 표3에는 습식화학환원법으로 합성한 Ni분의 해립처리전후의 BET법에 의한 비표면적과 TAP밀도의 값을 보여주고 있다. 해립처리된 Ni분은 해립미처리 Ni분과 비교하여 비표면적이 작고 TAP밀도가 높은 값을 보여주고 있다. 이것은 응집입자가 해립처리에 의해 단분산 입자화 되고 있는 것이라고 사료된다.
3. 전극 paste 특성
3.1 paste GREEN 밀도
적층 세라믹 콘덴서의 내부전극 paste는 응집입자가 없고 일차입자가 균일한 단분산입자로 되어 있지 않으면 안된다. 단분산 정도는 충진밀도로 평가된다. GREEN밀도를 ρg, 분말의 건조밀도를 ρd, 분말의 중량함유율을 Xd라고 하면, 충진밀도 P는 아래 식으로 표시된다.
P = ρg Xd / ρd (4)
식(4)에 의해 얻어진 충진밀도의 결과는 습식화학환원법의 Ni분 충진율의 경우 해립처리전의 37.5%에사 해립처리후의 60.2%로 크게 향상되고 있다. 이로부터 충진밀도를 무압성형으로 얻어 8배위충진상태(60.45%)의 경우의 이론 밀도로부터 계산하여 구한 잔존 공극율은 약 0.3이며 응집입자가 일차입자로 해립되어지는 것을 알수있다. 또한 CVD법에 의해 합성한 Ni paste 해립처리한 습식화학환웝에 의한 Ni paste를 교반기로 단순혼합하여 혼합시간에 대해 그린밀도의 변화의 차이를 그림6에 보여준다.
이것으로 해립처리한 습식화학환원법에 의한 Nipaste는 CVD법에 의해 합성한 Ni paste와 비교하여 높은 그린 밒도가 평균적으로 얻어진다. 따라서 분산해립한 Ni분말은 교반기등의 단순혼합에도 고분산성을 발휘하여 전극 paste를 green sheet에 인쇄하면 분말이 촘촘히 매운 상태로 인쇄할수 있다고 이해된다.
3.2 paste 표면조도
스크린 인쇄로 형성된 paste 표면은 평활과 동시에 핀홀이 모두 없을 필요가 있다.
한편 다시 고적층화가 요구되어지는속에 한층당 전극막 두께는 점점 얇아지는 경향이 있으며 특히 고적층콘덴서용 Ni paste에서는 균일한 전극 끊김과 동시에 우수한 평활도가 요구된다. 그래서 습식화학환원으로 합성한 Ni 분말 해립처리없는 Ni분과 해립처리한 Ni분을 각각 paste로 만들 경우 표면조도를 비교하였다. 그결과를 그림 6(a)(b)에 나타내고 있다.
해립처리한 Ni분에 미리 바인더를 용해한 TERPINEOL 용액을 첨가하고 고속진동혼합기(대연화학공업(주)제적 MKR-300)으로 예비혼합후, 교반기로 단순혼합한 paste에는 그림과 같이 표면조도는 0.13㎛ Ra , Rmax도 1.85㎛로 매우 요철이 미미하다.
한편 이것과 비교하여 같은 방법으로 paste화한 해립처리 Ni분은 표면조도가 0.05㎛, Rmax도 0.58로 극히 평활하였다. 이상으로 해립처리한 Ni분은 해립으로 고적층 세라믹 콘덴서에 매우 요구되고 있는 평탄과 동시에 핀홀이 생기기 어려운 거의 일차입자부터 되어 균일한 막이 형성할수 있게 된다. 한편 CVD법에 의해 합성한 Ni분 paste와 해립처리한 습식화학환원법으로 합성한 Ni분 paste를 교반기로 단순혼합하고 혼합시간에 대해 표면조도 변화를 측정하여 이것을 그림 7에 나타내었다. 여기서 해립처리 습식화학환원법으로 합성한 Ni분 paste는 CVD법에 의해 합성한 Ni분 paste와 비교하여 평활도가 매우 우수하였다. 따라서 분산해립한 Ni분은 교반기등의 단순혼합으로도 고분산성을 발휘하는 것이 보여진 것이다.
결론
필자들의 연구의 결과를 중심으로 액상법중에서도 습식화학환원법으로 단분산구상분말의 합성하는 방법을 두가지 소개하였다. 그리고 그 방법으로 합성한 단분산입자는 입경도 임의로 제어가능하며 현재시장의 흐름인 세라믹 콘덴서의 내부전극용 paste에 의해 요구되는 특성을 십분 만족하는 것이 가능하게 되었다. 한편 이후 박층 고적층화 시대에는 현재 주류인 일차 입경(0.5㎛-1.0㎛)보다 더 작은 일차입경(0.1㎛-0.5㎛)의 초미립자분말이 사용되는 것은 명확하며 그 분체 및 전극 paste 특성을 파악하는 것이 특히 중요하다.
본 논문에서는 액상법을 발전시킨 핵생성과 핵입자의 성장이라는 2단계성장법으로 단분산금속입자의 합성법과 합성후에 존재하는 응집입자를 일차입자로 해립하는 해립분산기술을 소개하였다. 21세기를 맞이하는 지금, 이러한 방법이 각광을 받을 때가 바로 밑까지 오고 있는 것처럼 느껴진다.
'2001-적층세라믹 콘덴서의 개발과 재료기술 및 고신뢰성화' 카테고리의 다른 글
| 제6장 3절 희토류 원소의 점유위치 (0) | 2021.04.03 |
|---|---|
| 제4장 2절 전극재료 합성기술 - CVD (0) | 2021.04.03 |
| 제6장1절 세라믹 콘덴서의 소성기술과 구조결함제어 (0) | 2021.04.03 |
| 제5장 2절 적층 성형 기술 (0) | 2021.04.03 |
| 제3장 각종 합성법에 의한 유전체재료의 특징 (0) | 2021.03.30 |




